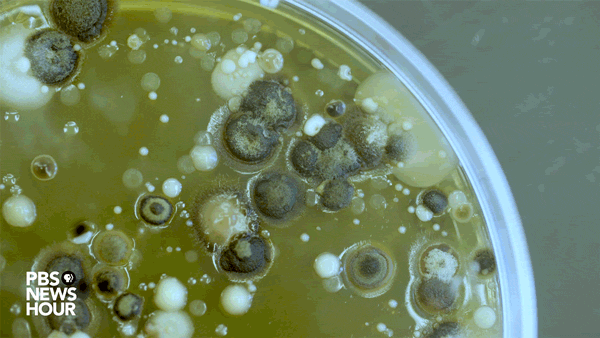
Forest of microbes A petri dish covered with the many microbes from a wasp's body. Photo by Matt Ehrichs

Anne Madden bends creatures to her will, with the deftness of a shepherd. But Madden is a microbe wrangler — her critters cover petri dishes. Rather than merely observe bacteria and fungi, Madden sees a community ready for work. If not for fungi, bacteria-fighting penicillin or heart-saving statins would not exist. If not for bacteria, the world would not have pickles. PICKLES!
“We have to find it. We have to bring it into the lab, and then we have to convince it to do something,” Madden told the NewsHour inside a lab at North Carolina State University in Raleigh, where she works as an environmental microbiologist.
These days, her experiments are buzzing, as she takes microbes — yeast — from bees and convinces them to brew beer.
But don’t fret. It’s less gross than it sounds. No “mass bug-icide” was committed, and no insect body parts feature in the final suds.
Rather, the discovery of bumblebeer yeast recalls a serendipitous science at the heart of beer history — and may also represent the first new yeast in 600 years capable of making traditional beer.
Bumblebeer bubbles to the surface
Bumblebeer began in 2014, as an academic science fair project.
Rob Dunn, an applied ecologist at North Carolina State University, had joined forces with the campus research brewer John Sheppard to develop a science-themed exhibit for the World Beer Festival — due to be held the next year in Raleigh.
Dunn was recruited because of his reputation for revealing the unseen organisms in our everyday lives. Over the years, his lab has conducted a series of bug censuses and found all sorts of freeloaders.
The survey revealed that an ordinary home contains up to 200 types of bugs…One project had citizen scientists in Raleigh swab for dust around their houses, in search of trace DNA left behind by critters. The survey revealed that an ordinary home contains up to 200 types of bugs, a thriving ecosystem of carpet beetles, aphids, cockroaches, paper wasps, spiders and silverfish.
That’s not even the strangest part.
“So far, we’ve found that wealthy people have more kinds of insects in their houses, which some people loved, other people didn’t like that so much,” Dunn joked in his office covered with antique maps and glass cases full of bees, flies and butterflies.
When the team expanded the survey to more than 700 homes nationwide, they discovered dust mites — whose feces and corpses trigger allergic reactions and asthma — are most abundant on the East Coast. Need respiratory relief? Head West.

Invasive allergies. As part of a bug census, Rob Dunn’s lab surveyed the geographical distributions of insects that cause allergies (dust mites) and indoor pests (ladybugs). Photo by Madden AA et al., Molecular Ecology, 2016.
Another census revealed that giant Japanese camel crickets, an invasive species, have “moved basement to basement across North America totally unnoticed,” Dunn said. “People don’t like them because they jump at you out of the dark.”
The team estimated that 700 million of these thumb-sized crickets might exist across the eastern United States alone — which may ultimately work in our favor. They found new kinds of bacteria from the guts of these crickets can break down a waste product of the paper industry and turn it into energy.
Few labs are equipped to find such microbes and bugs in such random environs, so if anyone could find a beer-making germ in the wild, it was Dunn’s team.
But where to start?
Dang, this yeast smells good
Beer, wine and other booze is made with yeast — single-celled microorganisms from the fungus kingdom. More than 1,500 yeast species are known around the world, and yet humans have essentially relied on only two types of alcohol-producing yeast — ale yeast and lager yeast — since the earliest days of brewing 9,000 years ago.
That’s because our partnership with beer-making yeast likely began by accident and evolved through happenstance. Scientists didn’t even realize yeast were living organisms until the 1830s, and it took Louis Pasteur another 20 years to discover how the microbes take sugars and chemically transform — ferment — them into alcohol.
Yeast microbiologists believe the earliest brewers were flying blind, driven by the sweet smells made when yeast ferment a wet pile of sugar-rich grains or a piece of fruit rotting in an orchard.
“It’s easy to imagine people thinking this smells just right to make a good bread. It smells just right to make a good beer, I’m going to save it,” Dunn said. And from that came bread, sourdough and beer recipes, passed down through generations.

Yeast feast. Aside from beer, other foods made with yeast include cottage cheese, ketchup, sauerkraut, soy sauce, vinegar and yogurt. Photo by Getty Images
Those smells arise from an ancient relationship between yeast and insect pollinators, Madden said.
Yeast live in flower nectar, where the microbes feast on boatloads of sugar. The yeast produce alcohol, along with those sweet aromas that tickle our noses, which in turn attract the buzzing bugs. Bees sometimes get drunk off this fermented nectar.
But flowers and fruits wilt in the cold of winter, which would kill the yeast too, meaning the microbes need a place to escape.
“So the question remains, where are yeasts in the winter, where are yeasts hiding in the world?,” Madden asked. “Yeasts are particularly bad at moving themselves from place to place. They don’t have a lot of the skillsets that other microbes or other larger organisms have.”
So the yeasts hitch rides on the insect pollinators, as they move from flower to flower. She said researchers had found winery yeasts in the winter on the bodies of hibernating wasps, which visit these sugar sources during the summer.
“We actually think, based on some work from colleagues in Italy, it’s very likely that those first beers and breads were relying on yeasts from insects too,” Dunn said. Madden and Dunn began with a plan: to intercept yeast as they rode on bees or wasps, in hopes of finding one to make alcohol.
But wild animals are filthy, covered or filled with thousands of microbes. You can’t just drop a bee into juice and hope for fermentation. Madden would need to combine her senses and modern microbiology.
Forest of microbes. A petri dish covered with the many microbes from a wasp’s body. Photo by Matt Ehrichs
She started in North Carolina fields, where she caught a single paper wasp — a bug known to harbor large communities of yeast. She then transferred every microbe from its body to a petri dish. A couple days later, a forest of microbes appear on the dish.
First, she looked to separate the yeast from other fungi or bacteria on the plate. “It’s about understanding when something glistens in a certain way,” Madden said. “It has got a different color than others. It’s slightly less slimy.” Next, she picked a handful of yeast candidates, grew them on a new dish and followed her nose. Fermenting yeast smell pleasant due to compounds called “organoleptics” that they make from sugar. The fruity and biscuity notes define the final taste of the beer.
Her third task was running the DNA from these candidates through a National Institutes of Health database to ensure her picks weren’t related to pathogens. The final stage is a color-coded chemical test because to make beer, the yeast must be able to process maltose — a sugar found in malted barley. If the yeast can’t use those sugars, they are not going to produce alcohol.
If the test tube turns bright yellow, then the yeast is a winner and ready for the brewhouse.
Wild yeast, banished
So far, Madden has found two yeasts, one from a single wasp and one from a single bee, capable of making beer.
“To make all of the different bumblebeers that we’ve made, we’ve killed two bugs. You’ve likely killed more bugs on your way to a bar to get beer.”“People tend to ask us how many insects died to make beer, and the answer is very few. Once the yeast is separated, we can use the yeast for eternity without going back to those insects” Madden said. “To make all of the different bumblebeers that we’ve made, we’ve killed two bugs. You’ve likely killed more bugs on your way to a bar to get beer.”
Her picks landed with John Sheppard, the North Carolina State research brewer, who found that bumblebeer yeast sits on unique pedestal in brewing. Many wild yeasts are considered contamination in the domestic beer industry because they produce a lot of off flavors, Sheppard said.
But once upon a time, wild yeast were unavoidable in alcohol production. It’s pretty easy to contaminate your food when you don’t know microorganisms cover every inch of your body…and pretty much everything else.
The first brewers recognized that the top portion of a beer barrel could be saved and reused to brew a consistent product. Little did they know it also contained a microbial stew made primarily of ale yeast (species: Saccharomyces cerevisiae). Sure, every now and again, their batches might get skunked by the other microbes in the stew — hello, sour beer! But the practice worked well in warmer regions where civilizations began.
The tactic became less viable as folks moved into the colder climates of Germany and northern Europe, where the Big Bang of brewing ultimately happened.

Tale of two yeast. Only two species of yeast — ale yeast (Saccharomyces cerevisiae; pictured above) and lager yeast — have been used for traditional beer brewing for the last 600 years. A lab in North Carolina may have found a third in the strangest place: On bees. Photo by Mogana Das Murtey and Patchamuthu Ramasamy/via Wikimedia
In the early- and mid-1400s, Bavarian brewers stumbled upon lager yeast, which was technically the crud left behind in the bottom of the barrel.
“All of a sudden, they could now brew at colder temperatures and get crisper cleaner flavors,” said Chris Todd Hittinger, a University of Wisconsin geneticist who isn’t involved with the bumblebeer project.
Cold brewing made beer less likely to spoil, and sparked the domestic age of beermaking. In April 1516, Bavaria issued Reinheitsgebot — a “purity order” — that limited beer’s ingredients to barley malt, water, hops and bottom fermenters (lager yeast).
Add the steam engine and colonialism, and lager-style beers eventually spread across the world. Today, cold-adapted lager yeast account for 90 percent of global beer markets, Hittinger said, such as for big brands like Miller, Budweiser, Heineken, Stella Artois and Corona. Ale yeast became reserved for the speciality menu: pale ales, India pale ales, stouts, porters and wheat beers.

Paper carrier. Madden started her search in North Carolina fields, where she caught a single paper wasp — a bug known to harbor large communities of yeast. Photo by Lauren Nichols
Ale yeast and lager yeast became the standard bearers, because they make significant quantities of alcohol without adding natural flavors, Sheppard said.
They’re basic Beckys — bland and easily influenced, with more in common than early brewers could have guessed.
Thirty years ago, modern genetics revealed lager yeast to be a “living descendent” of ale yeast — created when the latter mated with a yeast strain identified as Saccharomyces eubayanus in 2011 by Hittinger and Argentine biologist Diego Libkind. Moreover, domestication pushed these strains through a genetic bottleneck, forcing them to produce more and more alcohol while simultaneously losing their traits needed for survival in the wild.
And wild yeast? To brewers, wild yeast became the smelly friend you forget to invite to parties — banished by everyone except for imbibers of sour beers, where a funky taste is sought.
Wild yeast, rising
Enter bumblebeer yeast. It’s wild, yet can make traditional lager-style beer without stank flavors. But using bumblebeer yeast, Sheppard can also tweak the fermenting conditions, so a honey flavor emerges without adding honey. Tweak them again, and he can brew a light tangy sour beer.
“The adaptable nature to these wild yeast means if you change the conditions, they’re going to give you quite different flavor profiles in the beer,” Sheppard said.
The bumblebeer team is particularly interested in sour beers, which are usually difficult to concoct.
“It’s true. The traditional sour beer process is much more complicated, because you have this community of organisms that starts the fermentation,” Hittinger said.
People nab these unconventional organisms from inconceivable places. (One brewer in Oregon made a sour beer from wild yeast pulled from his beard.) But as a result of their unpredictability, a typical sour beer takes months or years to make.
Bumblebeer does the same job in a couple of weeks. Dunn, Madden and Sheppard have patented and licensed these strains, which are Lachancea yeast — a group that diverged from ale and lager yeast 100 million years ago. Other researchers have tested Lachancea strains for beer production, but the bumblebeer strains are the first slated for commercialization. That’s partially because bumblebeer yeast, under the right conditions, pumps out 10 times more acid than these other strains, which is what creates the tangy taste of sour beer.

Bee(r) on display. A visitor checks out the bumblebeer exhibit at the 2015 World Beer Festival in Raleigh. Photo by Lauren Nichols
“There are more traits that differ as relate to mouth feel, flavor and aroma and industrial performance,” Madden said.
They have also laid foundation needed to repeat the feat of discovering beer-producing strains in the wild.
“[Bumblebeer] might be a new type of beer that’s somewhere between a sour beer and an ale beer,” Hittinger said.
North Carolina’s Deep River Brewing rolled out the first suds made from bumblebeer yeast earlier this year.
“So we’ve worked recently with one species of camel cricket, one bumblebee, one wasp — and we’ve found three things useful to society,” Dunn said. “Two are new yeasts for making beers, one is a new kind of bacteria for breaking down waste.”
Now just imagine what might be hiding in the millions of unknown insects across globe, Dunn continued.
“Who knows what we could discover there? It could be new compounds for medicine. It could be even more new yeasts for beer. It could be new bacteria that help us make energy.” Dunn said.
“And we’ve barely started to look.”
ncG1vNJzZmivp6x7sa7SZ6arn1%2Bjsri%2Fx6isq2ejmLamusKeZqedqKl6qa3PqbBmoJ%2Bqv26u1LOxZpqipMKotNNmmZ6dow%3D%3D